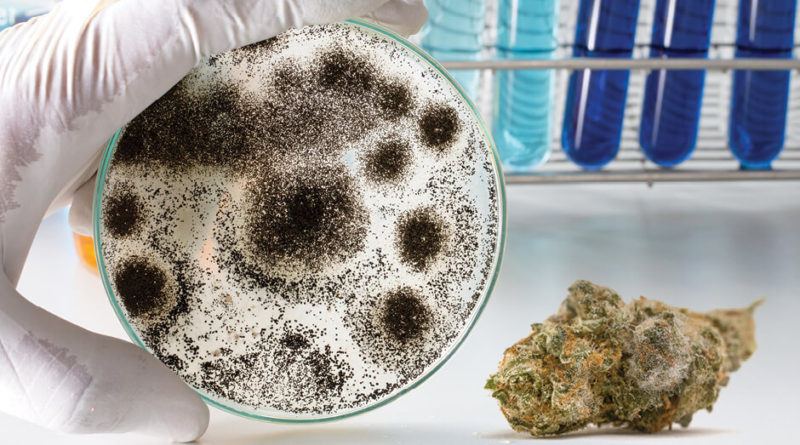

It’s Time to Mandate Aspergillus Testing for Cannabis
It’s no secret most marijuana produced in the US is ultimately consumed by inhalation — smoking, vaping, dabbing, and more. These methods of consumption are generally safe, at least in the short term, but they are not without risk.
With the COVID-19 pandemic continuing for the foreseeable future and the “vape crisis” of 2019 lingering in the cannabis industry’s recent history, our industry and regulators need to bring a renewed focus to respiratory risks facing medical marijuana patients and other marijuana consumers.
Microbial contamination — specifically testing for four known potentially deadly species of Aspergillus that can colonize the lungs of marijuana users who have inhaled contaminated product — is an obvious place to start, but several states still do not require it. Some states screen for “total yeast and mold counts” — but that type of screening has historically been used for orally-administered pharmaceuticals and food products. The route of administration matters, and that fact makes this type of screening inadequate for marijuana products that are generally inhaled.
Email Newsletter
Join thousands of other growers who are already receiving our monthly newsletter.
Read also: Mystery Cannabis Virus Identified
The traditional methods for enumerating total yeast and mold counts (TYMC) involve “plating” the samples on nutrient-rich media that supports growth of general yeast and mold fungi. The plates are then counted for yeast and mold colonies, called “colony-forming-units” (CFUs), and the result represents the total fungal bioburden in the sample.
Nobody wants moldy cannabis and consumers should not have to think twice about that being a possibility. The TYMC provides marijuana consumers some level of assurance the products they buy have a reasonable upper limit of naturally occurring yeast and mold, which are unavoidable for marijuana or any other botanical product.
But, when implemented without screening for toxic Aspergillus species, the TYMC data are incomplete — and potentially dangerously deceiving. That’s because with culture-based methods, it is nearly impossible to visually distinguish between species of Aspergillus using culture plate techniques. A. flavus, A. fumigatus, A. niger (brasilliensis), and A. terreus are known to be infectious in humans and may result in significant health complications — including the colonization of lungs, where they can reproduce and grow into “fungal balls” that live and thrive in the marijuana user’s lungs.
Read also: Tips for Preventing Mold Growth in the Grow Room
On the contrary, there are many microbes that are beneficial and approved for use in cannabis horticulture but are benign to humans. These microbes, like rhizobia fungi, might grow on yeast and mold plate counts, giving an otherwise undue failure. At the same time, a cannabis product could have 9,000 colony-forming-units (CFUs) per gram of a pathogenic Aspergillus species and still “pass” under some states’ medical marijuana limits — the “recommended” standard set forth in the American Herbal Products Association’s early, highly influential, but nonetheless incomplete and, today, outdated Cannabis Inflorescence monograph published in 2014.
Moving Beyond Plating Samples
It’s time to move beyond “plates.”
Molecular methods — quantitative polymerase chain reaction (qPCR) testing (a type of the broader category of PCR testing that checks DNA profiles of target organisms like Aspergillus) has been commercially available to cannabis labs at reasonably affordable prices for several years now and has been an integral part of the medical laboratory world for decades. Indeed, PCR, invented by Dr. Kary Mullis in the 1980s, led to a Nobel Prize and what we know today as the “DNA test.”
There are several types of PCR assays targeting DNA and RNA. The DNA variants generally involve amplifying a DNA signature in the “target” organism of interest — more specifically, a known DNA segment or sequence that is unique to the target organism or species. This aspect of PCR gives it remarkably high specificity for the target organism while excluding background noise from off-target species.
Read also: The Art of Curing Your Cannabis Crop
Bottom line, if Aspergillus is identified in a sample, the odds of a “false positive” are low, and the cannabis batch from which the sample was taken is almost certainly contaminated (assuming no accidental contamination of the sample between the point of sampling and the point of testing). Those batches that fail are a threat to public health and safety, and the number of “false” failures (“failing” marijuana that was not truly contaminated, and was otherwise fit for consumption) is low — meaning cultivators and processors face near-zero risk of being forced to destroy or remediate “failed” batches.
The risk of loss of harvest batches, driving up costs for cultivators, processors, and consumers is always a factor that must be considered. As a recent study pointed out, “losses inflicted by destroying cannabis that fails testing is a major component of overall costs.”
In the case of Aspergillus, destruction is not even required as a matter of patient safety, which should remove one major concern cultivators and processors might otherwise have. In cases where Aspergillus is detected, the contamination can be destroyed and the marijuana’s biologically active ingredients can be salvaged for use in edibles, topicals, and other non-inhalational routes.
In reality, the occurrence of pathogenic microbial contaminants is very rare in today’s well-regulated cannabis industries. But the odds are not zero and the risks are more severe when dealing with medicinal marijuana patients who may already be more vulnerable.
The cannabis industry is in its infancy for most states. There should be an ongoing effort to continue evaluating the existing regulations, new advances in testing technologies, and the best execution of it all. The vaping crisis last year and the current COVID-19 pandemic only reinforce the need for accurate and reliable testing so consumers can trust the safety of the products they use and avoid unnecessary respiratory risks.
Read next: Peace-of-Mind Microbial Remediation